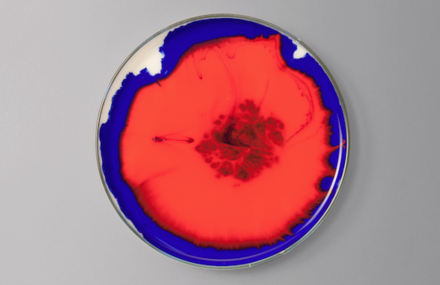

C’est dans les eaux turquoises de la côte de Cabo Pulmo au Méxique, lors d’une...
78
Custom your daily dose of inspiration
Access to exclusive content and new products before everyone else
Add to favorites your articles on Fubiz
C’est dans les eaux turquoises de la côte de Cabo Pulmo au Méxique, lors d’une...
78